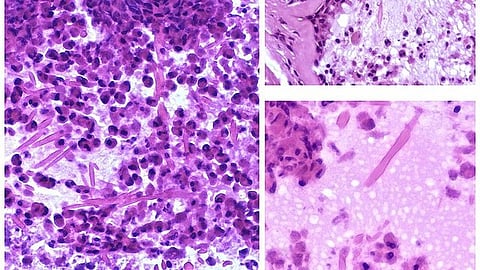
Mysteries in Chronic Rhinosinusitis (Representational image: Wikimedia Commons)

INDIANAPOLIS—An Indiana University School of Medicine surgeon-scientist is leading a multi-institutional grant investigating the role of the sinus microbiome in chronic rhinosinusitis, an inflammatory disease that causes the lining of the sinuses to swell. The research team will study biospecimens from human sinus surgery patients in the lab and examine how bacteria in the microbiome shape the disease process and might offer novel therapeutic strategies.
Vijay Ramakrishnan, MD, professor of otolaryngology—head and neck surgery and a primary member of Stark Neurosciences Research Institute, has spent over a decade investigating the microbiome. The five-year, $2.9 million grant from the National Institute of Allergy and Infectious Diseases, part of the National Institutes of Health, is a first-of-its-kind grant studying the physiological effect of the sinus microbiome on chronic rhinosinusitis.
The microbiome is an accumulation of microorganisms—bacteria, fungi and viruses—that live within areas of the human body, such as the gut and sinus cavities. These microbes can shape a person’s health, predispose people to disease, act as disease modifiers and influence how people respond to specific treatments. In chronic rhinosinusitis, scientists believe microbes and bacteria play a role in sinus inflammation beyond a person’s traditional sinus infection.
“The upper airway is heavily colonized with bacteria, and the different types of influence immune processes and the general function of the surface lining,” Ramakrishnan said. “If we can steer the microbiome into a favorable healthy state, there are some functions that we can influence to maybe get us better treatment results.”
Ramakrishnan will work with researchers at the University of Colorado School of Medicine, led by Daniel Frank, PhD. Ramakrishnan started his research of the microbiome when he was a faculty member at the University of Colorado; he joined IU School of Medicine in January 2022.
Chronic rhinosinusitis affects nearly 10% of adults in the United States. Most patients manage the disease medically through sinus rinses, nasal spray medications and allergy treatments. It’s estimated, however, that 15% of chronic rhinosinusitis patients pursue sinus surgery, where most cases result in subpar outcomes, Ramakrishnan said. The volume of chronic rhinosinusitis cases, he added, is expected to rise due to climate change, pollution and western diet.
Antibiotics have long been prescribed for chronic rhinosinusitis—it’s one of the top conditions for antibiotic use, according to the Centers for Disease Control and Prevention—but they haven’t shown to be effective in treating most patients, Ramakrishnan said. The disease is now viewed as inflammatory rather than infectious, creating a need to develop new treatment strategies.
“This problem is very prevalent in adults. There’s only a handful of therapies, and they work about 75% of the time,” Ramakrishnan said. “Understanding the role of microbiome in this disease and focusing clinical approaches to restrict antibiotic use are our two main health outcomes.”
Researchers will collect biospecimens of surgical patients to investigate host-microbial processes in airway mucosal immunology. They’ll also use cell cultures to test how various microorganisms impact disease processes and initiate specific immune responses.
The grant also supports a longitudinal multi-institutional human intervention study of chronic rhinosinusitis surgical patients. The research team will investigate patient outcomes, medication use and how the microbiome of patients changes over time, Ramakrishnan said.
Ramakrishnan said this study moves beyond prior small observational studies by defining molecular, cellular, and immunological processes using a multi-omics approach, which incorporates data derived from transcriptomics and metabolomics.
The team will collaborate with Thomas O’Connell, PhD, associate professor of otolaryngology—head and neck surgery, to conduct tissue metabolomics and with IU network scientists at the Luddy School of Informatics, Computing, and Engineering at IU Bloomington to do a physics-based approach to understand networks of interaction between disease and patient outcomes and tissue-level multi-omics.
“We’re trying to figure out which chronic rhinosinusitis patients have a microbial component that we can influence, to steer them to better outcomes and allow their own bodies to restore health, thereby limiting antibiotic use and number of interventions,” Ramakrishnan said. (SB/Newswise)